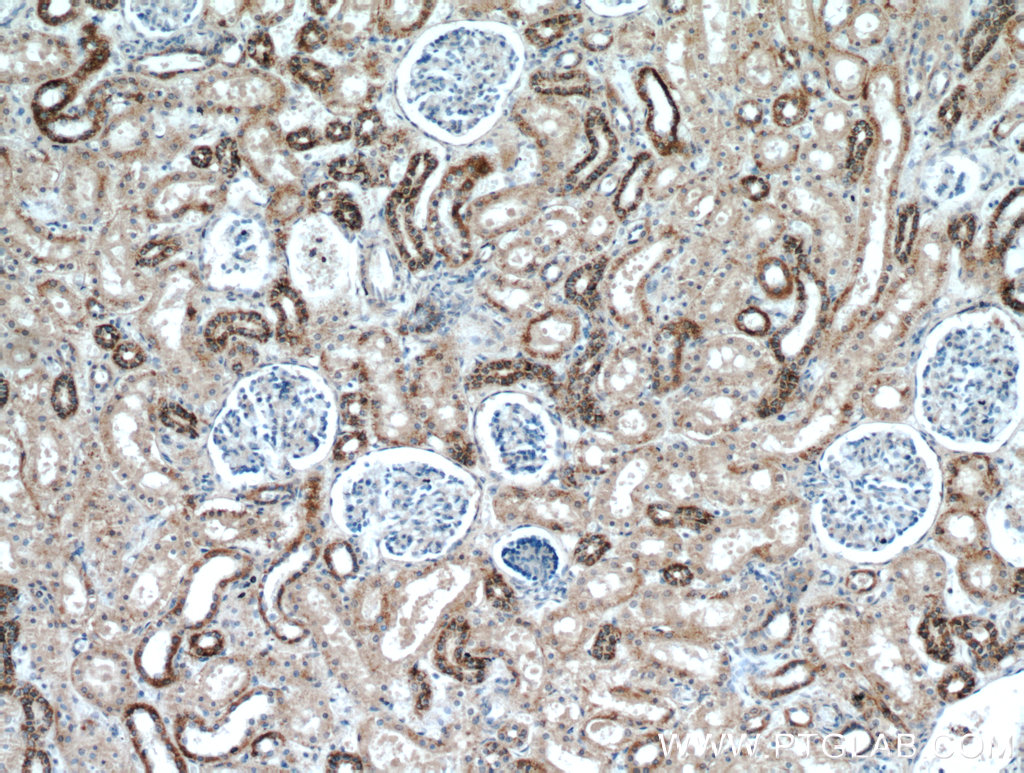

验证数据展示
经过测试的应用
| Positive WB detected in | HEK-293 cells, mouse kidney tissue, human heart tissue, human brain tissue, K-562 cells, mouse brain tissue, A549 cells, HeLa cells, rat brain tissue, HFF cells, MRC-5 cells |
| Positive IP detected in | HEK-293 cells, HFF cells |
| Positive IHC detected in | human kidney tissue, human brain tissue, mouse brain tissue, mouse kidney tissue Note: suggested antigen retrieval with TE buffer pH 9.0; (*) Alternatively, antigen retrieval may be performed with citrate buffer pH 6.0 |
| Positive IF/ICC detected in | hela cells, HEK-293 cells |
推荐稀释比
| 应用 | 推荐稀释比 |
|---|---|
| Western Blot (WB) | WB : 1:500-1:1000 |
| Immunoprecipitation (IP) | IP : 0.5-4.0 ug for 1.0-3.0 mg of total protein lysate |
| Immunohistochemistry (IHC) | IHC : 1:20-1:200 |
| Immunofluorescence (IF)/ICC | IF/ICC : 1:200-1:800 |
| It is recommended that this reagent should be titrated in each testing system to obtain optimal results. | |
| Sample-dependent, Check data in validation data gallery. | |
产品信息
20170-1-AP targets KGA-Specific in WB, IHC, IF/ICC, IP, CoIP, ELISA applications and shows reactivity with human, mouse, rat samples.
| 经测试应用 | WB, IHC, IF/ICC, IP, ELISA Application Description |
| 文献引用应用 | WB, IHC, IF, CoIP |
| 经测试反应性 | human, mouse, rat |
| 文献引用反应性 | human, mouse, rat |
| 免疫原 |
CatNo: Ag14002 Product name: Recombinant human GLS protein Source: e coli.-derived, PGEX-4T Tag: GST Domain: 616-669 aa of BC038507 Sequence: KDRWNNTPMDEALHFGHHDVFKILQEYQVQYTPQGDSDNGKENQTVHKNLDGLL 种属同源性预测 |
| 宿主/亚型 | Rabbit / IgG |
| 抗体类别 | Polyclonal |
| 产品类型 | Antibody |
| 全称 | glutaminase |
| 别名 | GLS, KGA, AAD20, EC:3.5.1.2, GAC |
| 计算分子量 | 669 aa, 73 kDa |
| 观测分子量 | 66 kDa |
| GenBank蛋白编号 | BC038507 |
| 基因名称 | GLS |
| Gene ID (NCBI) | 2744 |
| RRID | AB_10665373 |
| 偶联类型 | Unconjugated |
| 形式 | Liquid |
| 纯化方式 | Antigen affinity purification |
| UNIPROT ID | O94925 |
| 储存缓冲液 | PBS with 0.02% sodium azide and 50% glycerol, pH 7.3. |
| 储存条件 | Store at -20°C. Stable for one year after shipment. Aliquoting is unnecessary for -20oC storage. |
背景介绍
GLS, also named as GLS1 and KIAA0838, belongs to the glutaminase family. It catalyzes the first reaction in the primary pathway for the renal catabolism of glutamine. Glutaminase-, glutamate-, and taurine-immunoreactive neurons develop neurofibrillary tangles in Alzheimer's disease.The glutaminase band in AA/C1 cells is more intense than in HT29 cells, in accordance with measurements of glutaminase activity, and had the same molecular mass of approx 63 kDa. The bands for both cell lines are clearly different in size from both rat liver glutaminase (58 kDa) and rat kidney glutaminase (65 kDa)(PMID:12408749). It also reveals a molecular weight of 83-84 kDa as a phosphate-dependent glutaminase(PMID:447624;7512428). It has 3 isoforms produced by alternative splicing named as KGA, GAM, GAC. This antibody is specific to KGA.
实验方案
| Product Specific Protocols | |
|---|---|
| IF protocol for KGA-Specific antibody 20170-1-AP | Download protocol |
| IHC protocol for KGA-Specific antibody 20170-1-AP | Download protocol |
| IP protocol for KGA-Specific antibody 20170-1-AP | Download protocol |
| WB protocol for KGA-Specific antibody 20170-1-AP | Download protocol |
| Standard Protocols | |
|---|---|
| Click here to view our Standard Protocols |
发表文章
| Species | Application | Title |
|---|---|---|
Nat Med Metabolic reprogramming induces resistance to anti-NOTCH1 therapies in T cell acute lymphoblastic leukemia. | ||
Cell Stem Cell CRISPR-Mediated Induction of Neuron-Enriched Mitochondrial Proteins Boosts Direct Glia-to-Neuron Conversion. | ||
Blood Targeting glutaminolysis has anti-leukemic activity in acute myeloid leukemia and synergizes with BCL-2 inhibition. | ||
Elife Metabolic reprogramming of cancer cells by JMJD6-mediated pre-mRNA splicing associated with therapeutic response to splicing inhibitor | ||
Cell Death Discov O-GlcNAcylation of glutaminase isoform KGA inhibits ferroptosis through activation of glutaminolysis in hepatoblastoma
| ||
Int J Mol Sci Mitochondrial Metabolism behind Region-Specific Resistance to Ischemia-Reperfusion Injury in Gerbil Hippocampus. Role of PKCβII and Phosphate-Activated Glutaminase. |